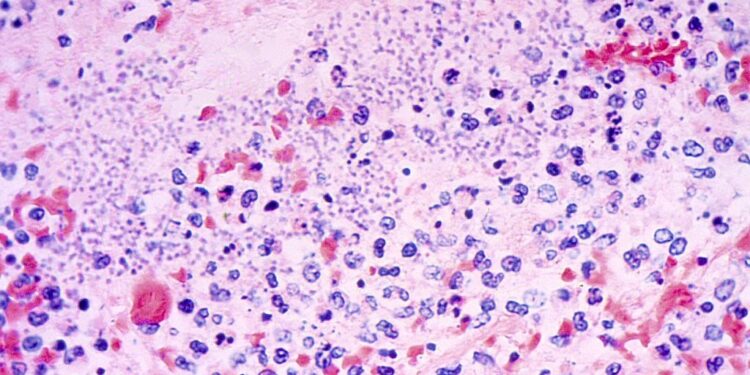
What to Know About Pneumonic Plague After Arizona Demise

An individual in Arizona has died from pneumonic plague, native well being officers mentioned on Friday.
Pneumonic plague, which happens when the bacterium Yersinia pestis will get into an individual’s lungs, is each “the least frequent and most harmful sort of plague,” in response to the Cleveland Clinic.
All three main kinds of the plague are uncommon within the modern-day. One sort, bubonic plague, was the primary explanation for the fourteenth century’s Black Demise pandemic, which left a path of dying and devastation throughout Europe. Now, roughly 1,000 to 2,000 individuals throughout the globe are recognized with plague yearly, per the Cleveland Clinic. Solely round seven instances are reported within the U.S. annually.
It’s unclear when the individual in Arizona died, however the Coconino County well being division mentioned in a press launch that it acquired take a look at outcomes Friday that confirmed the affected person had pneumonic plague.
Right here’s what to find out about pneumonic plague.
The place do most instances of plague occur, and who’s most susceptible to an infection?
In recent times, plague has mostly been present in Africa, in response to the World Well being Group. It stays endemic in some international locations, primarily the Democratic Republic of Congo, Madagascar, and Peru.
“Within the U.S., you’re extra more likely to get plague in rural areas of western states,” in response to the Cleveland Clinic. “You’re at larger danger when you work with animals in an space the place plague is discovered.”
How does pneumonic plague unfold?
Pneumonic plague is the one sort of plague that may be transmitted from individual to individual, in response to the U.S. Facilities for Illness Management and Prevention (CDC). Particular person-to-person transmission can occur by means of coughing and sneezing, in response to the Cleveland Clinic. However an individual may additionally get the illness after shut contact with an animal contaminated with it, or from micro organism transferring from one other a part of the physique to the lungs.
Generally, plague usually spreads by means of bites from fleas that had bitten an animal contaminated with the micro organism.
Based on the CDC, U.S. officers haven’t documented person-to-person unfold of plague within the nation since 1924, however “there proceed to be uncommon instances of pneumonic plague amongst individuals uncovered to sick cats.” Cats, the CDC mentioned on its web site, “are significantly vulnerable to plague and will be contaminated by consuming contaminated rodents.”
How can I shield myself in opposition to it?
The Cleveland Clinic advises individuals to attenuate their danger of plague by avoiding flea bites and exercising warning round animals that might be contaminated with the micro organism. The clinic recommends taking actions together with carrying bug spray with DEET, carrying gloves when coping with animals that might be contaminated, and never permitting pets to wander round exterior if situated in an space that’s identified to have plague.
A plague vaccine is just not presently accessible within the U.S., in response to the CDC. Whereas scientists are engaged on creating such vaccines within the U.S., the CDC mentioned, they “will not be anticipated to be commercially accessible within the speedy future.”
Globally, the World Well being Group recommends vaccination in opposition to plague just for high-risk teams, together with well being care employees and other people working in laboratories who’re in fixed hazard of publicity.